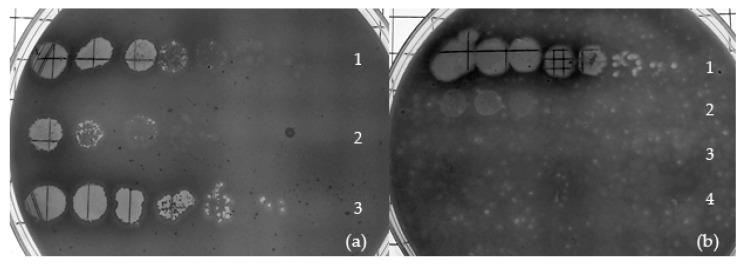

一种新型放线菌 Tectiviridae 属。
A Novel Genus of Actinobacterial Tectiviridae.
机构信息
Department of Biological Sciences, University of Maryland Baltimore County (UMBC), Baltimore, MD 21250, USA.
Keith R. Porter Imaging Facility, University of Maryland Baltimore County (UMBC), Baltimore, MD 21250, USA.
出版信息
Viruses. 2019 Dec 7;11(12):1134. doi: 10.3390/v11121134.
and are two novel members of the family. These phages were isolated on cultures of the plant pathogen , known for its worldwide economic impact on potato crops. Transmission electron microscopy showed viral particles with double-layered icosahedral capsids, and frequent instances of protruding nanotubes harboring a collar-like structure. Mass-spectrometry confirmed the presence of lipids in the virion, and serial purification of colonies from turbid plaques and immunity testing revealed that both phages are temperate. and have linear dsDNA chromosomes (18,266 bp and 18,251 bp long, respectively) with the characteristic two-segment architecture of the . Both genomes encode homologs of the canonical tectiviral proteins (major capsid protein, packaging ATPase and DNA polymerase), as well as PRD1-type virion-associated transglycosylase and membrane DNA delivery proteins. Comparative genomics and phylogenetic analyses firmly establish that these two phages, together with , form a new genus within the , which we have tentatively named . The identification of a cohesive clade of Actinobacteria-infecting tectiviruses with conserved genome structure but with scant sequence similarity to members of other tectiviral genera confirms that the are an ancient lineage infecting a broad range of bacterial hosts.
和 是 科的两个新成员。这些噬菌体是从植物病原体 的培养物中分离出来的,该病原体因其对全球土豆作物的经济影响而闻名。透射电子显微镜显示,病毒粒子具有双层二十面体衣壳,并且经常出现带有领状结构的突出纳米管。质谱分析证实了病毒粒子中存在脂质,混浊斑块的菌落连续纯化和免疫测试表明这两种噬菌体都是温和噬菌体。 和 具有线性 dsDNA 染色体(分别为 18266bp 和 18251bp),具有 的典型两段式结构。两个基因组都编码经典 tectivirus 蛋白(主要衣壳蛋白、包装 ATP 酶和 DNA 聚合酶)的同源物,以及 PRD1 型病毒相关转糖基酶和膜 DNA 递呈蛋白。比较基因组学和系统发育分析明确将这两种噬菌体与 一起确立为 科内的一个新属,我们暂定名为 。带有保守基因组结构但与其他 tectivirus 属成员的序列相似性很少的放线菌感染 tectivirus 的凝聚分支的鉴定证实, 是感染广泛细菌宿主的古老谱系。